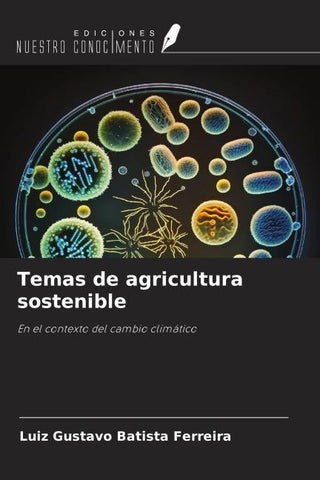
Temas de agricultura sostenible

Autorenfreundlich Bücher kaufen?!

Beschreibung
En el contexto del cambio climático
Details
| Verlag | Ediciones Nuestro Conocimiento |
| Ersterscheinung | 22. Juni 2025 |
| Maße | 22 cm x 15 cm x 0.4 cm |
| Gewicht | 96 Gramm |
| Format | Softcover |
| ISBN-13 | 9786208990787 |
| Seiten | 52 |